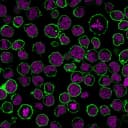

Anti-CD43 (T-Cell Marker) (rSPN/839)
CAT:
37-BNUB2220-500
Size:
500 µL
Price:
Ask
- Availability: 24/48H Stock Items & 2 to 6 Weeks non Stock Items.
- Dry Ice Shipment: No

Anti-CD43 (T-Cell Marker) (rSPN/839)
- Description: This antibody recognizes a cell surface glycoprotein of 95/115/135 kDa (depending upon the extent of glycosylation), identified as CD43 . Epitope of MAb Bra7G is clearly different from that of MAb rSPN/839, called "b" as opposed to "a" for rSPN/839. 70-90% of T-cell lymphomas and from 22-37% of B-cell lymphomas express CD43. No reactivity has been observed with reactive B-cells. So a B-lineage population that co-expresses CD43 is highly likely to be a malignant lymphoma, especially a low-grade lymphoma, rather than a reactive B-cell population. When CD43 antibody is used in combination with anti-CD20, effective immunophenotyping of lymphomas in formalin-fixed tissues can be obtained. Co-staining of a lymphoid infiltrate with anti-CD20 and anti-CD43 argues against a reactive process and favors a diagnosis of lymphoma.Primary antibodies are available purified, or with a selection of fluorescent CF® Dyes and other labels. CF® Dyes offer exceptional brightness and photostability. Note: Conjugates of blue fluorescent dyes like CF®405S and CF®405M are not recommended for detecting low abundance targets, because blue dyes have lower fluorescence and can give higher non-specific background than other dye colors.
- Synonyms: Galactoglycoprotein, GALGP, GPL115, Leukocyte sialoglycoprotein, Leukosialin, LSN, Sialophorin, SPN
- CAS Number: 9007-83-4
- UNSPSC: 41116161
- UNSPSC Description: Primary and secondary antibodies for multiple methodology immunostaining detection application
- Gene Name: SPN
- Gene ID: 6693
- NCBI Gene ID: 632188
- UniProt: P16150
- Cellular Locus: Plasma membrane
- Host: Mouse
- Species Reactivity: Human
- Immunogen: Recombinant full-length human CD43 protein
- Target Antigen: CD43
- Clonality: Recombinant Monoclonal
- Isotype: IgG1
- Clone: rSPN/839
- Conjugation: Purified, with BSA
- Disease: Tumor
- Source: Animal
- Applications: Flow (verified) | IF (verified) | IHC, FFPE (verified) | WB (verified)
- Validated Applications: FC, IF, IHC, FFPE, WB
- Field of Research: Immunology
- Positive Control: Paracortex in a tonsil or a reactive lymph node
- Concentration: 0.2 mg/mL
- Buffer: PBS, 0.05% BSA, 0.05% azide
- Molecular Weight: 95, 115, or 135 kDa
- Additionnal Information: Higher concentration may be required for direct detection using primary antibody conjugates than for indirect detection with secondary antibody|Immunohistology (formalin): 0.5-1 ug/mL for 30 minutes at RT|Staining of formalin-fixed tissues requires boiling tissue sections in 10 mM citrate buffer, pH 6.0, for 10-20 minutes followed by cooling at RT for 20 minutes|Optimal dilution for a specific application should be determined by user
- Shipping Conditions: Room temperature
- Storage Conditions: 4°C; Stable at room temperature or 37°C (98°F) for 7 days.
- Shelf Life: 2 years